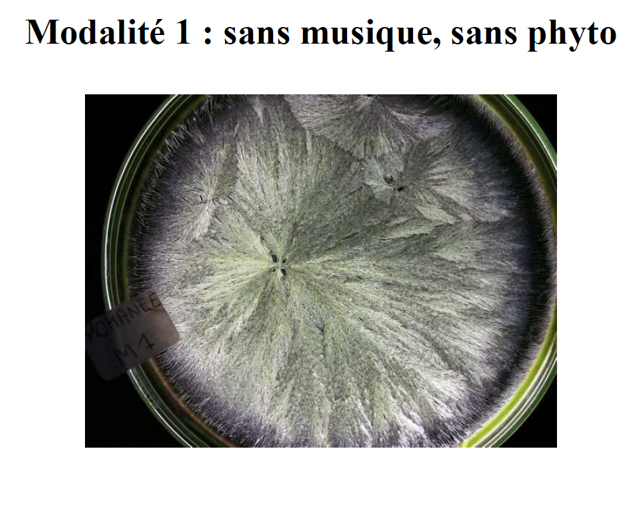
Images de morpho-cristallisation comparatives modalités 1
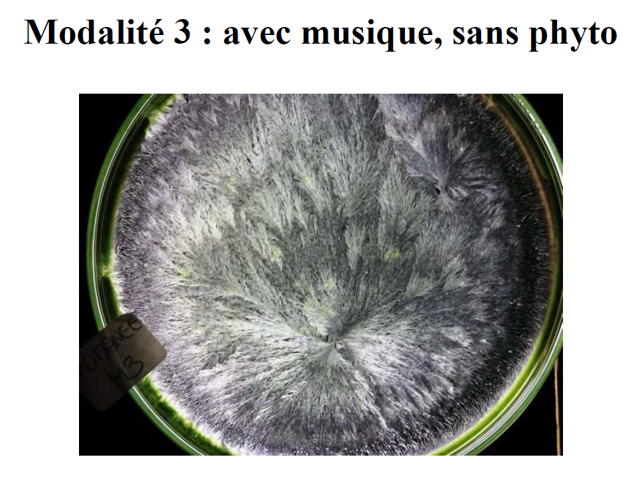
Images de morpho-cristallisation comparatives modalités 3

3. Résultats des Études de Cas
3.1. Cas d'étude 1 : Vignoble de Buzet (2015-2018)


| Paramètre | Avant Traitement | Après Traitement | Amélioration |
|---|---|---|---|
| Parcelle UB 233 (3,34 ha) | |||
| Taux de mortalité moyen | 7,68 % | 2,37 % | -70,84 % |
| Pieds morts (moyenne) | 818 unités | 138 unités | 2318 pieds préservés en 4 ans |
| Cépage | Cabernet Sauvignon (3500 pieds/ha) | ||
| Réduction annuelle | |||
| - Année 2016 | -66,99 % | ||
| - Année 2017 | -70,17 % | ||
| - Année 2018 | -73,11 % | ||
3.2. Cas d'étude 2 : Domaine du Bois-des-Dames (2018-2021)

| Caractéristique | Détails |
|---|---|
| Localisation | Violès, Côtes-du-Rhône |
| Surface traitée | 20 ha (parcelle de 1450 m de long) |
| Cépage | Mourvèdre |
| Année de plantation | 2003-2005 (5 îlots) |
| Densité | 2,20 x 1,10 m (103 rangs orientés Nord-Sud) |
| Taux de mortalité initial | 4 à 7 % par an |
| Durée de l'étude | 4 années (2018-2021) |
| Objectif | Réduction de la mortalité annuelle causée par l'Esca |

3.3. Synthèse des Études Nationales (2008-2019)
L'analyse statistique de l'ensemble des projets menés par Genodics révèle des résultats significatifs à grande échelle :
| Cas d'étude | Nombre de parcelles | Surface (ha) | Pieds analysés | Résultat | IC |
|---|---|---|---|---|---|
| Cas 1a Réduction de l'impact de l'Esca |
17 parcelles | 43 ha | ~200 000 | Diminution de ~1,5% en an 1 Stabilisation entre 1-2% les années suivantes |
- |
| Cas 1b Prévention et réduction de l'Esca (avec moyennes historiques) |
91 parcelles | 260 ha | 1 209 020 | Diminution moyenne de 57% dès la 1ère année Stabilisation entre 50-65% du taux initial |
99% |
| Cas 1c Prévention et traitement avec parcelle témoin |
2 parcelles (traité vs témoin) |
- | - | 38-80% de symptômes en moins sur la parcelle génodique vs témoin |
- |



3.4. Études Qualitatives : Morpho-cristallisation (2010)
Une étude comparative menée par Margarethe Chapelle du Laboratoire Thiollet a évalué la qualité du raisin selon 4 modalités de traitement du mildiou :
| Modalité | Musique (Genodics) | Traitement Phyto | Évaluation Qualitative |
|---|---|---|---|
| 1 | ❌ | ❌ | Produit racé et équilibré mais fragilité due au botrytis |
| 2 | ❌ | ✅ | Plus de force mais moins fin et moins mature que modalité 1 |
| 3 | ✅ | ❌ | « Des quatre modalités, c'est sans contestation aucune la plus complète et la plus équilibrée » Rassemble toutes les qualités attendues : solidité, complexité, finesse, élégance, race |
| 4 | ✅ | ✅ | Similitudes avec modalité 2, mais avec plus de finesse et bon potentiel qualitatif |

3.5. Résultats sur d'Autres Pathologies
| Culture | Pathologie | Agent Pathogène | Résultat |
|---|---|---|---|
| Vigne | Mildiou | Champignon | Réduction d'un facteur 6 |
| Courgette | Mosaïques | Virus (WMV2, ZYMV) | Réduction de la virulence |
| Endive | Pourriture | Bactérie (Erwinia) | Réduction d'un facteur 2 des endives de 2nde catégorie |
